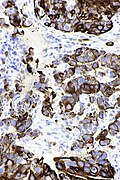

Cytokeratin 20
(Redirected from CK20)
Jump to navigation
Jump to search

CK20 staining in small intestine.
Cytokeratin 20, abbreviated CK20, is a commonly used immunostain. It is also known as keratin 20.
Positive
CK20 positive and CK7 negative
- Virtually all colorectal carcinomas.[1]
- Merkel cell carcinoma - perinuclear dot-like pattern.
- Eosinophilic, solid and cystic renal cell carcinoma - an evolving entity.
Partially CK20 positive
- Corticotrophic pituitary adenomas and Crooke-hyaline changes.[2]
CK20 positive and CK7 positive
- Pancreatic adenocarcinoma.
- Ovarian mucinous carcinoma.
- Occasionally stomach adenocarcinoma, cholangiocarcinoma.
- Urothelial carcinoma.
- Esophageal adenocarcinoma.
Images
See also
References
- ↑ Chu, P.; Wu, E.; Weiss, LM. (Sep 2000). "Cytokeratin 7 and cytokeratin 20 expression in epithelial neoplasms: a survey of 435 cases.". Mod Pathol 13 (9): 962-72. doi:10.1038/modpathol.3880175. PMID 11007036.
- ↑ Eschbacher, JM.; Coons, SW. (2006). "Cytokeratin CK20 is a sensitive marker for Crooke's cells and the early cytoskeletal changes associated with hypercortisolism within pituitary corticotrophs.". Endocr Pathol 17 (4): 365-76. PMID 17525485.